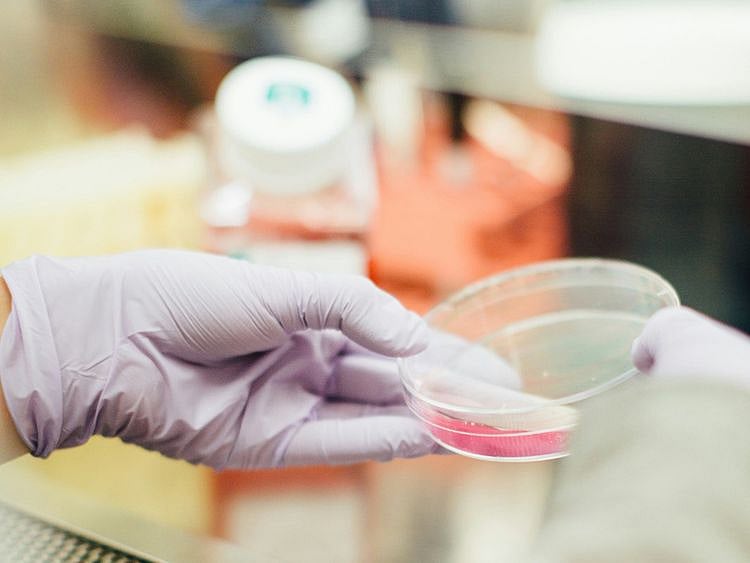
Stock-Kelix-Bio-(Mubadala)

“The agreements build on Mubadala’s efforts to establish an Abu Dhabi based national pharma champion, which will enhance the UAE’s pharma infrastructure, address the nation’s most prevalent diseases, reduce healthcare expenditure, strengthen the UAE’s drug security and set another milestone towards a resilient, knowledge-based economy,” the statement said.
Sign up for the Daily Briefing
Get the latest news and updates straight to your inbox
Network Links
GN StoreAbout Gulf NewsTerms & ConditionsReach by GNSitemapContact usPrivacy PolicyGN FocusHave your sayWork with usAdvertise with usGulf News epaperPrinting Services
Download our app
© Al Nisr Publishing LLC 2026. All rights reserved.